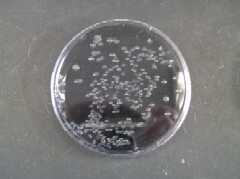

衛研ニュース レジオネラ症とその検査法
レジオネラ症とは
レジオネラ属菌が原因で起こる感染症です。レジオネラ症には、レジオネラ肺炎(在郷軍人病)とポンティアック熱の2つの病型があります。
レジオネラ肺炎は、多臓器不全を起こして発病から1週間以内に死亡する劇症型のものから、適正な抗生物質治療で治癒する様々な病態のものがあります。ポンティアック熱は、高熱を発し、インフルエンザ様の症状を示しますが2~3日で自然治癒します。
レジオネラ属菌は本来土壌細菌であり、自然界に広く生息しています。一方で冷却塔、給水給湯設備、循環式浴槽などの人工環境でも生物膜の中にひそんでいる場合があり、このような環境から発生したエアロゾルを吸入することで感染します。
そのため予防するには、以下のような対策が重要です。
- 清掃、消毒を徹底し、住処となる生物膜を作らせない
- レジオネラ属菌が増殖する温度(20~45℃)を外した温度管理をする
- エアロゾルの発生を抑える
レジオネラ属菌について
一般性状
大きさは0.3~0.7×2~5μmのグラム陰性桿菌で、ほとんどの菌種が極鞭毛を持ちます。
増殖因子としてL-システインと鉄を要求し、ほとんどの糖を酸化も発酵もせず、エネルギー源としてアミノ酸を利用しています。
至適発育温度は36℃ですが、糖を利用できないという性質と栄養要求性が特殊なことから、通常の培地では発育できません。
特徴
細胞内寄生菌であることが最大の特徴です。
人に感染した場合には肺胞マクロファージなどに、環境中ではアメーバなどの原生動物の細胞内に入り込むことではじめて増殖が可能となります。つまりレジオネラ属菌が増殖している環境はレジオネラ属菌以外の生物でも汚染されている、ということです。
前述の通り、レジオネラ属菌は発育にL-システインなどのアミノ酸と鉄を要求しますが、細胞内はこれらの物質が豊富で利用しやすい環境となっていると考えられています。
このため通常の細菌分離用の選択培地や血液寒天培地では発育できず、臨床の現場ではレジオネラ肺炎を疑ってレジオネラ属菌を対象とした検査をしない限り、菌を分離することはできず、菌分離による診断をつけることはできません。
検査
衛生研究所では、保健所が採水した公衆浴場の浴槽水等のレジオネラ属菌検査を実施しています。
方法は厚生労働省通知等を参考にして行います。
吸引ろ過で100倍に濃縮した検水をそのまま、または酸で処理してGVPC培地などのレジオネラ属菌選択培地に接種し、37℃で7日間培養します。
レジオネラ属菌が10cfu(注1)/100ml以上存在すると写真1、2のような灰白色のコロニーができます。このコロニーをBCYEα培地(L-システイン含有)と血液寒天培地(L-システイン不含)に画線し、BCYEα培地(L-システイン含有)でのみ生えること(増殖にシステインを要求すること)を確認し、さらに検査を進めてレジオネラ属菌と同定します。
この結果は保健所へ通知され適切な指導へとつながります。
(注1)cfu ;colony forming unit

生物膜(バイオフィルム) レジオネラ属菌の住処
生物膜(いわゆる、ぬめり)とは、壁面に付着した微生物が増殖するとともに、粘液性物質を体外に産出し、これらが混在、結合して形成されたものです。冷却塔の水槽や充填材の表面、各種配管系の内部(特にその継ぎ手や曲折部で水流が遅滞する部分)、浴槽の内壁およびその循環ろ過装置の内部などには、生物膜が形成され、細菌、真菌、原生動物など微生物の住処となります。
生物膜からは、水流その他の条件に応じて装置内の水(または湯)に微生物が供給され、生物膜の内部にいる微生物は、消毒剤その他、外界からの不利な要因から保護されていると考えられます。
関連情報
このページに関するお問い合わせ
健康福祉局衛生研究所 生物科学部
〒733-8650 広島市西区商工センター四丁目1番2号
電話:082-277-6998(生物科学部) ファクス:082-277-0410
[email protected]